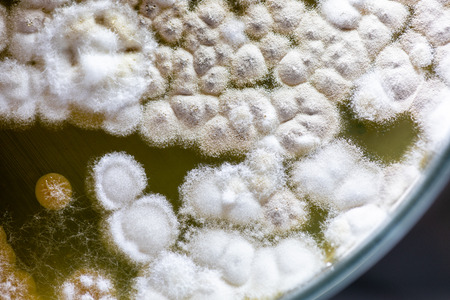
Colony characteristic of Actinomyces, Bacteria, yeast and Mold on selective media from soil samples for study in laboratory microbiology.の写真素材

写真素材 - Colony characteristic of Actinomyces, Bacteria, yeast and Mold on selective media from soil samples for study in laboratory microbiology.
作品情報
Colony characteristic of Actinomyces, Bacteria, yeast and Mold on selective media from soil samples for study in laboratory microbiology.
- ID:120031808
- 作品種別:写真
- 作者名:sinhyu
キーワード
- abstract
- actinomyces
- agar
- analysis
- background
- bacteria
- bacterial
- bacterium
- biology
- biotechnology
- characteristic
- colonies
- colony
- culture
- danger
- dirty
- disease
- dish
- education
- equipment
- experiment
- germs
- growing
- growth
- healthcare
- hygiene
- identification
- isolated
- lab
- laboratory
- media
- medical
- medium
- micro
- microbial
- microbiology
- mold
- organism
- pattern
- petri
- plate
- research
- sample
- science
- soil samples
- species
- test
- texture
- white
- yeast
類似作品
Different bacte...
Mold Beautiful,...
Close up of ras...
Veillonella bac...
Biohazard sign ...
Backgrounds of ...
Bacterial T-str...
Bacteria macro ...
close-up of bac...
Green mold grow...
Characteristics...
Backgrounds of ...
Backgrounds of ...
Microscopic Vie...
Backgrounds of ...
detail of bacte...
Microbiology
bacteria colony...
Colony of bacte...
Surface contami...
Close-up of bac...
A school experi...
bacteria colony...
Rusty old steel...
Staphylococcus ...
Macro close up ...
Mold Beautiful,...
The human whipw...
Abstract yellow...
Petri dish with...
Close up of bac...
Scientific imag...
Bacteria Franci...
3D scientific i...
A colorful wate...
Bacillus sp. on...
Some jellyfishe...
Streptococcus p...
Mold Beautiful,...
development, re...
Colonies of dif...
Colony characte...
bacteria colony...
colored abstrac...
a close up imag...
Abstract Festiv...
Pomegranate in ...
Science and Lif...
petri dish with...